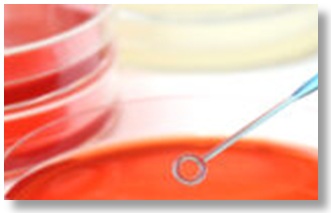

腸内細菌検査(検便)のご案内
弊社は、微生物検査のノウハウを生かし、各行政機関・全国の食品会社・工場の食品検査受託をはじめ、テーマパーク、大手スーパーマーケット、全国有名外食チェーン、給食センターなどから、定期腸内細菌検査や施設衛生検査など、全国の食品取り扱い従事者の方々に幅広くご利用いただいております。
厚生労働省登録検査機関・登録衛生検査所として、信頼と実績を誇る弊社の検査をご利用くださいますようお願いいたします。

保菌検査
安全・安心な食品・飲料水のご提供のため、以下の方々の腸内細菌検査(検便)についてご案内します。
1)食品営業施設で食品を直接取り扱う業務に従事している方
2)給食施設で働いている方
3)水道事業の浄水場などで働いている方
4)貯水場の清掃を業務としている方
定期検査や臨時検査の実施。全国チェーン店管理者、店舗管理者、部門管理者向けにそれぞれご希望の範囲の未提出者、検査結果をWeb・メール・FAXのご希望の方法でお知らせいたします。

保菌検査(検便)
安全・安心な食品・飲料水のご提供のため、以下の方々の腸内細菌検査(検便)についてご案内します。
1)食品営業施設で食品を直接取り扱う業務に従事している方
2)給食施設で働いている方
3)水道事業の浄水場などで働いている方
4)貯水場の清掃を業務としている方
定期検査や臨時検査の実施。全国チェーン店管理者、店舗管理者、部門管理者向けにそれぞれご希望の範囲の未提出者、検査結果をWeb・メール・FAXのご希望の方法でお知らせいたします。

ノロウイルス検査
ノロウイルスによる食中毒は全国的に食中毒発生件数及び患者数の第一位が続き、食品からの感染はもちろんのこと、ウイルス保有者がさわった食材からの感染も多数報告されています。ノロウイルスを保有していても症状を示さない人も多くいるため、定期的に検査を行うことが重要です。
陽性になった方のその後の陰性までの履歴管理もサポートします。
年中無休でノロウイルス検査を行っています。

寄生虫卵検査
xxxxxxxxxxxxxxxxxxxxxxxxxxxxxxxxxxxxxxxxxxxxxxxxxxxxxxxxxxxxxxxxxxxxxxxxxxxxxxxxxxxxxxxxxxxxxxxxxxxxxxxxxxxxxxxxxxxxxxxxxxxxxxxxxxxxxxxxxxxxxxxxxxxxxxxxxxxxxxxxxxxxxxxxxxxxxxxxxxxxxxxxxxxxxxxxxxxxxxxxxxxxxxxxxxxxxxxxxxxxxxxxxxxxxxxxxxxxxxxxxxxxxxxxxxxxxxxxxxxxxxxxxxxxxxxxxxxxxxxxxxxxxxxxxxxxxxxxxxxxxxxxx。

学園祭運営サポート
学園祭・文化祭の運営を衛生面からサポートします。
安全・安心な食品のご提供のため、食品を取り扱うみなさまの腸内細菌検査(検便)についてご案内します。
弊社の検査は、事前に検査対象者の名簿をお送りいただくだけの、手軽で簡単な検便システムになっています。
また、検体の受付や結果もWeb・メール・FAXのご希望の方法でお知らせいたします。